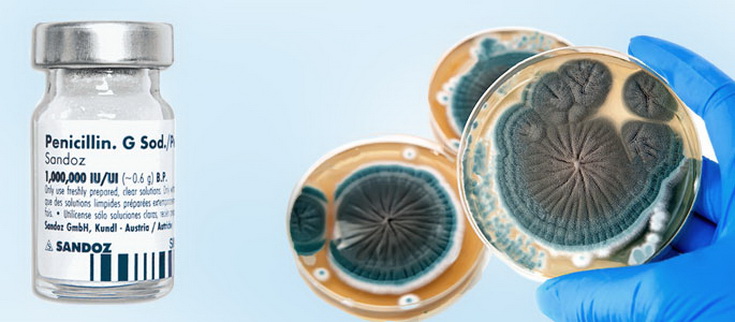
image

РУБРИКИ
06.02.2017/№6

Обладатель Нобелевской премии и британского дворянского титула биохимик Эрнст Чейн – сын уроженца Беларуси.
Трудно поверить, что три поколения назад смерть от безобидной инфекции была обычным явлением. Поворотным стал 1941 год. В феврале в Оксфорде на пациенте, умиравшем от осложнений из-за болячки в углу рта, испробовали новое средство – пенициллин. Инъекции улучшили его состояние, но запас драгоценной субстанции иссяк… Чудо случилось в июне – мальчика с прогнозом летального исхода от сепсиса препарат вылечил полностью. Среди тех, кто сделал это возможным и изменил ход развития медицины, был 35-летний биохимик Э.Чейн, сын уроженца Беларуси, будущий обладатель Нобелевской премии и британского дворянского титула.
Начало биографии
Сэр Эрнст Борис Чейн родился 19 июня 1906 года в Берлине. Его отец родом из Могилева. Окончив там гимназию, Михаэль Хаин учился и защитил диссертацию в Берлинском университете. Владел аналитической лабораторией и химическим заводом.
Под впечатлением от профессии отца Эрнст в 6 лет проявил интерес к химии, но дебютировал как пианист. Родители убедили его, что единственным стоящим занятием в жизни является интеллектуальная деятельность, а потому любая карьера, которая минует университет, немыслима. В 1924-м он поступил в Берлинский университет, изучал химию и физиологию. Потом работал в Институте патологии при университетской клинике, получил степень доктора.
Когда канцлером Германии стал А.Гитлер, Эрнст решил эмигрировать, надеясь, что нацисты пробудут у власти недолго. В апреле 1933 года он прибыл в Лондон. С октября работал в Институте биохимии Кембриджского университета. По совету его директора, Нобелевского лауреата Ф.Хопкинса, был зачислен также аспирантом. Через год стипендия от лондонской синагоги и «подъемные» от университета закончились, и Чейн (так теперь звучала его фамилия) жил на одну зарплату. В 1935-м защитил диссертацию по химии фосфолипидов.
Плесневый сок
29-летний обладатель двух ученых степеней еще колебался в выборе карьеры. Будущий «нобелист» Г.Кребс, тоже беженец из Германии, предлагал Эрнсту вообще забросить науку, поскольку он «точно лучший музыкант, чем биохимик». Дилемму разрешил случай.
В том году Школу патологии Оксфордского университета возглавил физиолог Х.Флори, уроженец Австралии. Бывший аспирант Хопкинса, он знал, что патологии не обойтись без химии. И решил создать группу биохимиков. Хопкинс порекомендовал Чейна, и тот стал лаборантом у Флори.
В начале 1938-го Эрнст прочел статью шотландца А.Флеминга, бактериолога из больницы в Лондоне, об угнетении роста болезнетворных бактерий пенициллиновой плесенью. Это наблюдение тот сделал в 1928-м, разглядывая микробные культуры в чашках Петри, не вымытых месяц назад после опытов. В одной из них колония стафилококка, взятого из гнойной раны, растворилась вблизи островка плесени, образованной грибком из рода Penicillium.
Фильтрат питательного бульона из-под грибка, который Флеминг окрестил «плесневым соком», а в статье – «пенициллином», ингибировал рост дифтерийной палочки, стафило-, стрепто-, гоно-, менинго- и пневмококков. Даже после разбавления в 800 раз! Инъекции «сока» не навредили мыши и кролику; не убивал он и лейкоциты в крови человека. Но испытать его действие на больных животных никто не подумал.
Флеминг сознавал, что «плесневый сок» – смесь неизвестного химсостава, но выделить активное вещество (позже и его назвали пенициллином) привычными для бактериолога приемами не мог. Поэтому даже в 1936 году его доклад о чудесной жидкости на всемирном конгрессе интереса не вызвал.
Зато Чейн убеждал Флори заняться природными ингибиторами, начав с опытов Флеминга. Шеф о «пенициллине» знал, но давно утратил к нему интерес.
Чудо-порошок
В конце 1938-го Эрнст узнал, что одна из сотрудниц хранит штамм грибка, полученный от Флеминга. Взятый у нее кусочек плесени он пестовал как мать дитя и вначале держал это в секрете. На испытание экстрактов выделений плесени уходили недели. А тут еще в 1939-м вновь на исходе были деньги.
Он предложил попытать счастья в Фонде Рокфеллера в Нью-Йорке. Идея сработала: за 5 военных лет им выделили почти 25.000 долларов! Обычно сдержанный Флори не скрывал радости – таких сумм он еще не знал.
Кто знает, это чейновский раздел заявки на грант убедил фонд, что у его плесени огромный потенциал терапевтического применения? Или слова Флори «Мне повезло иметь на кафедре д-ра Э.Чейна, который обладает, говорю это без колебаний, очень большим талантом к прояснению сути ферментативных и других биохимических проблем»?
К началу 1940-го Эрнст выяснил, что пенициллин – не белок и не фермент, не разрушается при слабых кислотности и щелочности экстракта и охлаждении до 0°C. Из «плесневого сока» его извлекали органическими растворителями, щелочью переводили в водный раствор. Сушка вымораживанием дала Чейну порошок, включавший натриевую соль пенициллина, но пока на 99% состоявший из примесей.
Не имея лицензии на проведение опытов на животных, Эрнст не раз просил Флори проверить экстракт на токсичность. Когда тот в присутствии дамы отчитал его за очередное приставание, униженный лаборант отправился к другу-токсикологу. Субстанцию ввели 2 мышам – побочных эффектов не было! Раздраженный походом Чейна к «чужому», Флори решил проводить опыты лично, хотя не умел попасть иглой в вену мыши. Их отношения дали трещину, зато шеф занялся пенициллином.
Лекарство века
Весной 1940-го Флори с помощниками испытали действие чейновского порошка на здоровых животных, с участием профессора-бактериолога – на штаммах микроорганизмов, а летом – в серии опытов на мышах, зараженных 3 видами патогенных бактерий. Из 74 получавших пенициллин 69 остались живы, все контрольные особи погибли.
Статья об этом вышла 24 августа. Через неделю с вопросом «Ну, что вы делали с моим старым пенициллином?» приехал Флеминг. От него ничего не скрыли, он ничего не похвалил, но увез образец препарата. А испытав его, написал Флори: «Вашим коллегам-химикам осталось только очистить активное вещество и синтезировать его».
Чейн и биохимик Э.Эбрахам хроматографией на окиси алюминия повысили степень очистки пенициллина, определили металлы, снижающие активность препарата, открыли разрушающий его фермент, выделяемый рядом бактерий. А после первой инъекции в январе 1941-го умиравшей пациентке очистили экстракт от примеси, вызывавшей лихорадку.
За 5 месяцев испытаний в лазарете пенициллин спас от смерти 4 из 6 тяжелобольных, уже не реагирующих на другие лекарства; еще 4-х излечил от глазных инфекций. Статья обо всех аспектах работы, спланированной и начатой Чейном и Флори (на это указали особо), доказала: найдено чрезвычайно эффективное средство химиотерапии, ингибирующее бактерии даже при разведении 1:2.000.000! И вызвала интерес к нему во всем мире.
Летом 1941-го в поисках производителей Флори с ассистентом уехали в США (Эрнст узнал об этом, увидев их с чемоданами). Американцы нашли новые штаммы, питательные среды и процессы ферментации, существенно повысившие выход и чистоту пенициллина. В марте 1944-го компания «Пфайзер» открыла первый в мире завод по его производству, через год «лекарство века» появилось в аптеках. Считают, что на сегодняшний день оно спасло жизни почти 90 млн человек.
Нобелевская в 39
В 1943-м, когда по обе стороны океана работы засекретили, Чейн применил хроматографию на силикагеле, что очистило бариевую соль пенициллина до 70–90%. Совместно с сэром Р.Робинсоном, вскоре президентом Королевского общества, химиком-органиком У.Бейкером и Эбрахамом он ломал голову над молекулярной структурой пенициллина.
Ученые споры были жаркими. Как-то Робинсон, автор одного из двух вариантов строения молекулы из 39 атомов, взбешенный возражениями Эрнста, запустил в него чернильницей и заявил, что больше не желает видеть «этого жалкого человечка». Сотрудничавшая с ними Д.Ходжкин в мае 1945-го, после 4 лет рентгеноструктурных исследований, доказала правоту Чейна.
К тому времени газеты и журналы пестрели измышлениями об «отце пенициллина» Флеминге как единственном достойном Нобелевской премии; Флори и Чейн упоминались как его «молодые сотрудники». Но победила истина. 25 октября 1945 года, будучи в Нью-Йорке, Чейн получил телеграмму о присуждении всем троим Нобелевской премии за открытие пенициллина и его лечебного действия при различных инфекционных заболеваниях. 30.000 долларов разделили между лауреатами поровну.
В 39 лет Эрнст получил первую в своей жизни научную награду – и сразу высшую! На его второй родине (он стал британским подданным в 1939-м) к этому отнеслись прохладно. Нужного ему оборудования не закупали. До весны 1949-го не избирали в Королевское общество, осенью он еще числился у Флори лаборантом. Лишь через 25 лет после Флеминга и Флори третьего лауреата удостоили титула рыцаря.
С 1948-го Чейн руководил в Риме Международным центром микробиологической химии с опытным ферментативным заводом. Вернулся в Англию в 1964-м и до выхода на пенсию возглавлял кафедру биохимии в Имперском колледже Лондона. Пионер исследований пенициллина умер 12 августа 1979 года в Ирландии, в графстве Мейо, где жил в последние годы.
Николай КОСТЮКОВИЧ,
кандидат физ.-мат. наук
ЗАГОЛОВКИ НОВОСТЕЙ
19.11.2025
ДНЕВНИКИ ОТЦА – ПАРТИЗАНСКОГО КОМАНДИРА
19.11.2025
СВИДЕТЕЛИ БЫЛЫХ ВРЕМЕН
19.11.2025
СОЮЗНЫЙ «Компонент-Ф»
19.11.2025
Его жизнь – большое путешествие
19.11.2025
СВЕРХТВЕРДЫЕ МАТЕРИАЛЫ КОНКУРИРУЮТ С АЛМАЗОМ
19.11.2025
БАНАНЫ, КОКОСЫ, АПЕЛЬСИНОВЫЙ РАЙ
19.11.2025
«МОЗГ» ЭКСПЕРИМЕНТАЛЬНОГО ЗАВОДА
19.11.2025
ЗВЕЗДЫ СОДРУЖЕСТВА
19.11.2025
АНТАРКТИДА УДИВИТ И БЫВАЛЫХ
19.11.2025
XI ФОРУМ РЕГИОНОВ РОССИИ И БЕЛАРУСИ
19.11.2025
МАСШТАБНАЯ ЗАДАЧА ДЛЯ МИКРООРГАНИЗМА
19.11.2025
БЕССТРАШНАЯ ПОДПОЛЬЩИЦА ИЗ АКАДЕМИИ НАУК
19.11.2025
ЛАКОКРАСОЧНЫЕ ТЕХНОЛОГИИ ПОД ЗАПРОС
19.11.2025
КЛЮЧ К СЕКРЕТАМ ВИДИМОГО И НЕВИДИМОГО
19.11.2025
У СВАІМ КУЛЬТУРНЫМ АСЯРОДДЗІ
19.11.2025
АНТАРКТИДА ГЛАЗАМИ ЭКОЛОГА
19.11.2025
